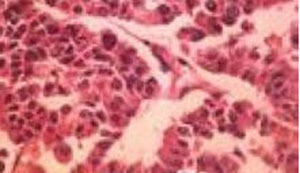
2A型和2B型多发性内分泌腺瘤病

2A型和2B型多发性内分泌腺瘤病
发布日期:2020.01.06 14:30:53
1968年Steiner等报道了一个家系,出现甲状腺髓样癌、嗜铬细胞瘤、甲状旁腺功能亢进(HPTH)及库欣综合征。出国看病机构爱诺美康了解到,该综合征被命名为2型多发性内分泌肿瘤,现在知道是MEN2A。目前认为,根据遗传性MTC的特征,有三种相关综合征:
MEN2A(OMIM#171400)、MEN2B(OMIM#162300)及家族性甲状腺髓样癌(FMTC)(OMIM#155240)。

出国看病机构爱诺美康了解到,大多数内分泌专家认为FMTC代表了MEN2A的变异体,不应该单独列为一个疾病类型。后来建议分为MEN2A和MEN2B两种综合征。而且,在MEN2A也有4种类型:经典型MEN2A,Hirschsprung病的MEN2A,皮肤苔藓样淀粉样变性的MEN2A和FMTC。
在遗传性甲状腺髓样癌MTC患者中,95%具有MEN2A,5%具有MEN2B。事实上,所有这些综合征均发生甲状腺髓样癌MTC,50%以上患者带有MEN2A和MEN2B将发展为PHEO。嗜铬细胞瘤PHEO几乎都是良性的,限定在肾上腺。单侧嗜铬细胞瘤PHEO患者在10年内通常发展为双侧嗜铬细胞瘤PHEO。遗传性MTC的生化和遗传实验的诊断发展之前,是PHEO而不是甲状腺髓样癌MTC为MEN2A患者极普遍的死亡原因。30%MEN2A患者出现甲状旁腺功能亢进(HPTH),常为中度或无症状。
MEN2B患者具有典型的面貌外观与马方综合征体型和非典型相貌。他们也有弥漫性神经节瘤和骨骼异常。
甲状腺髓样瘤来源于神经嵴的C细胞。C细胞分泌多肽激素降钙素(CTN)、癌胚抗原(CEA)。血清CTN作为MTC的良好标志物,出国看病机构爱诺美康介绍,目前主要用于检测甲状腺切除术后持续性或复发性甲状腺髓样癌MTC。甲状腺髓样癌MTC极有效的治疗是及时甲状腺切除术,极好在MTC还局限在甲状腺时进行手术。
甲状旁腺功能亢进-颌骨肿瘤综合征(HPT-JT,MIM145001),以常染色体显性遗传性甲状旁腺功能亢进、上颌骨或下颌骨的骨化性纤维瘤、肾囊肿或固体肿瘤、子宫纤维瘤的出现为特征。海外医疗机构爱...
下一篇:家族性孤立性垂体腺瘤家族性孤立性垂体腺瘤(FIPA,MIM102200),约5%的垂体肿瘤以家族性出现。美国看病机构爱诺美康了解到,家族性孤立性垂体腺瘤是一种常染色体显性遗传病,在同一个家族中至少有2例垂体肿瘤,不...
2025年ASCO年会上通过海报分享的亚组分析数据显示,在高危细胞遗传学患者中,通过荧光原位杂交定义为del(17p)、t(4;14)、t(14;16)或增益/安培(1q), CAR - t细胞治疗(n = 123)的中位PFS为37.1个月(95%...
出国看病:Talquetamab 对治疗多发性骨髓瘤安全且有效根据2025年ASCO年会上公布的1/2期MonumenTAL-1试验(NCT03399799/NCT04634552)的数据,Talquetamab-tgvs (Talvey)在复发/难治性多发性骨髓瘤患者中具有活性,显示出持久的缓解率。疗效数据显示,客观缓解率(O...
出国治疗:贝兰他单抗对改善具有细胞遗传学的骨髓瘤有应答根据最新的3期dream -8试验(NCT04484623)的回顾性分析结果,与泊马度胺、硼替佐米(Velcade)和地塞米松(PVd)相比,贝兰他单抗马福多汀(Blenrep)、泊马度胺(Pomalyst)和地塞米松(BPd)联合治疗至少有1个...
Darzalex 联合应用能在多发性骨髓瘤患者中产生应答根据在2025年ASCO年会上公布的一项针对3期CEPHEUS试验(NCT03652064)的临时亚组分析结果,在硼替佐米(Velcade)、来那度胺(Revlimid)和地塞米松(D-VRd)的基础上,达拉单抗(Darzalex)联合应用于硼替佐米(...
去美国看病:与 Ide-Cel 相比 Cilta-Cel 在 R/R 骨髓瘤中疗效更好一项回顾性分析比较了护理标准idecabtagene vicleucel(ide-cel;Abecma)和ciltacabtagene autol eucel(cilta-cel;Carvykti)在复发/难治性多发性骨髓瘤患者中表现出生存结果改善,但cilta-cel的毒性增加。发表在...
-
美国国家儿童医院 美国国家儿童医院对爱诺美康转诊资质的认证。
-
西达赛奈医疗中心 西达赛奈医疗中心对爱诺美康转诊资质的认证
-
皇家马斯顿医院 爱诺美康与皇家马斯顿医院达成服务共识。
-
加州大学洛杉矶分校医学中心 加州大学洛杉矶分校医学中心(UCLA Health)与爱诺美康签署正式合作协议。
-
丹娜法伯癌症研究院 丹娜法伯/布列根和妇女医院癌症中心对爱诺美康转诊资质的认证。
-
麻省总医院(1) 麻省总医院对爱诺美康转诊资质的认证(NO.1页)。
-
麻省总医院(2) 麻省总医院对爱诺美康转诊资质的认证(NO.2页)。
-
辛辛那提儿童医院 辛辛那提儿童医院(美国2018-2019儿童肿瘤排名NO.1)对爱诺美康转诊资质的认证。

MD安德森癌症中心
丹娜法伯癌症研究院
辛辛那提儿童医院
克利夫兰医学中心
纪念斯隆凯特琳癌症中心
Mayo Clinic 梅奥诊所
麻省总医院
肺癌
乳腺癌
结肠癌
淋巴瘤
肉瘤
宫颈癌
卵巢癌
脑瘤
奥希替尼耐药,只剩3个月生存期,“笨办法”让我再次用上肺癌靶向药
晚期乳腺癌生命只剩6个月,她能逆袭吗?
为了多活10年,我带妈妈去美国治疗淋巴瘤
不认命 我带父亲去麻省总医院看肺癌
成功可以复制,美国这家医院再次治好晚期乳腺癌
肿瘤复发,我去美国看病的日子
北京淋巴瘤患者赴美治疗后,体内癌细胞完全消失
疫情之下,美国肿瘤专家弛缓晚期肠癌患者